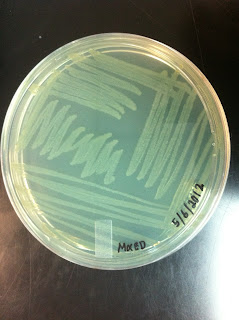

最近
周围的人
都有点闷闷不乐
好像乐不起来
How can I help you guys?
I miss every smiling face from you guys
single smile from all of you
will ready cheer my day up
I lost of motivation because of you guys
Really hoping to see your smile from sincere heart
再过两个星期
这学期又要结束了
太快了
但是我
思想
观念
好像有一丝丝的改变了
2012 已经过了一半
上半年我过得很好
下半年要更好
好好珍惜身边的一切吧~
每一天都有它们自己的意义
不会有重复~
ps: sorry a bit weird for the mixture of language post............
Have a break, enjoy reading
Thursday, June 28, 2012
Tuesday, June 19, 2012
Magic of Microbe
I fall in love with Microbe this semester
Is full of surprise every lab session
single swab on the agar
just like nothing
but
the next day
you will observe something
is COLONY
different shape
different color
Is full of surprise every lab session
single swab on the agar
just like nothing
but
the next day
you will observe something
is COLONY
different shape
different color
can anyone of you understand how I feel?
haha
I LOVE MICROBIOLOGY very much
爱,这回事
Love is always unpredictable
always change
depend on the person's heart, feeling and also environment
A successful relationship
normally happen
at the right time, right place with right feel
Dear reader,
you all may think that I falling in love or what
but
I still single
as usual
Just people surrounding me
make me feel so
some of them having sweet and romance relationship
some of them get hurt during the relationship
some of them scare to start a relationship
some of them considering how to start a relationship
For my opinion,
all of this is truly from the person heart
as long as u give him/her a sincerely heart
without and lie...........
that is the best part of the relationship
Wishes all of you having a happy life with your love one.............
depend on the person's heart, feeling and also environment
A successful relationship
normally happen
at the right time, right place with right feel
Dear reader,
you all may think that I falling in love or what
but
I still single
as usual
Just people surrounding me
make me feel so
some of them having sweet and romance relationship
some of them get hurt during the relationship
some of them scare to start a relationship
some of them considering how to start a relationship
For my opinion,
all of this is truly from the person heart
as long as u give him/her a sincerely heart
without and lie...........
that is the best part of the relationship
Wishes all of you having a happy life with your love one.............
Sunday, June 10, 2012
5th Semester of Degree
Study life passes as we blink our eyes
day past fast
as we busy for assignment
tests
and exams
this semester
we are arranged to take only two subject
Microbiology and BTE- Cell and tissue culture
the main point is
there is only THREE of us in the class
me, Germagne and Hui Xin
相依为命
at first we found it scary
because we have to 100% focus during the class
any one of us are dreaming in the class
will be called by the lecturer
but after two weeks of classes and lab
I found it quite good to have only three of us
because
During the class
we had paid full attention
therefore during quiz and test
we have less burden on studies........
a simple reading through the notes
will refresh the memory
this really good
first time have this type of feel
this made my life and studies easier
This semester only have 6-7week
without any breaks in between
hope three of us can flight for it
and go through it with excellent of result
day past fast
as we busy for assignment
tests
and exams
this semester
we are arranged to take only two subject
Microbiology and BTE- Cell and tissue culture
the main point is
there is only THREE of us in the class
me, Germagne and Hui Xin
相依为命
at first we found it scary
because we have to 100% focus during the class
any one of us are dreaming in the class
will be called by the lecturer
but after two weeks of classes and lab
I found it quite good to have only three of us
because
During the class
we had paid full attention
therefore during quiz and test
we have less burden on studies........
a simple reading through the notes
will refresh the memory
this really good
first time have this type of feel
this made my life and studies easier
This semester only have 6-7week
without any breaks in between
hope three of us can flight for it
and go through it with excellent of result
Sunday, June 3, 2012
习惯
有个朋友
从我开始到这里Nilai
就一起进进出出的
虽然之前我们有点口角
闹得不是很愉快
但
现在她要出国了
这个星期没有她的声音
还有一丝丝的不习惯
习惯是指长时期养成的不易改变的动作、生活方式、社会风尚等。。。。
事实总是残酷的
我惟有慢慢的再次习惯
顿时觉得有点点的空虚
加油!
Subscribe to:
Comments (Atom)